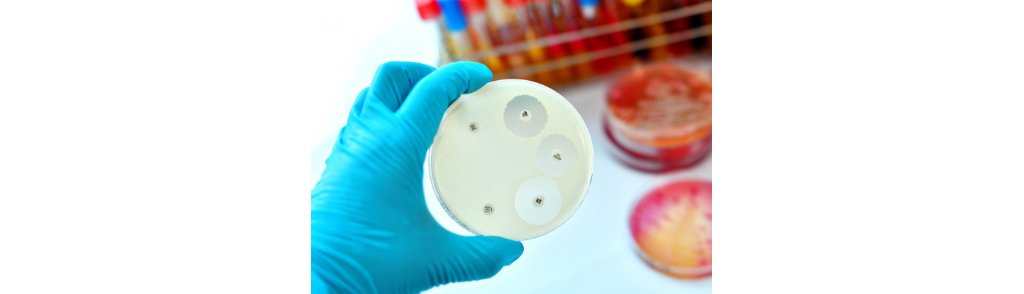

November 14, 2025
Working Paper: Global Economic Impacts of Antimicrobial Resistance
If you're a healthcare professional concerned about antimicrobial resistance (AMR), this working paper by Fernando and McKibbin offers a compelling economic case for action.